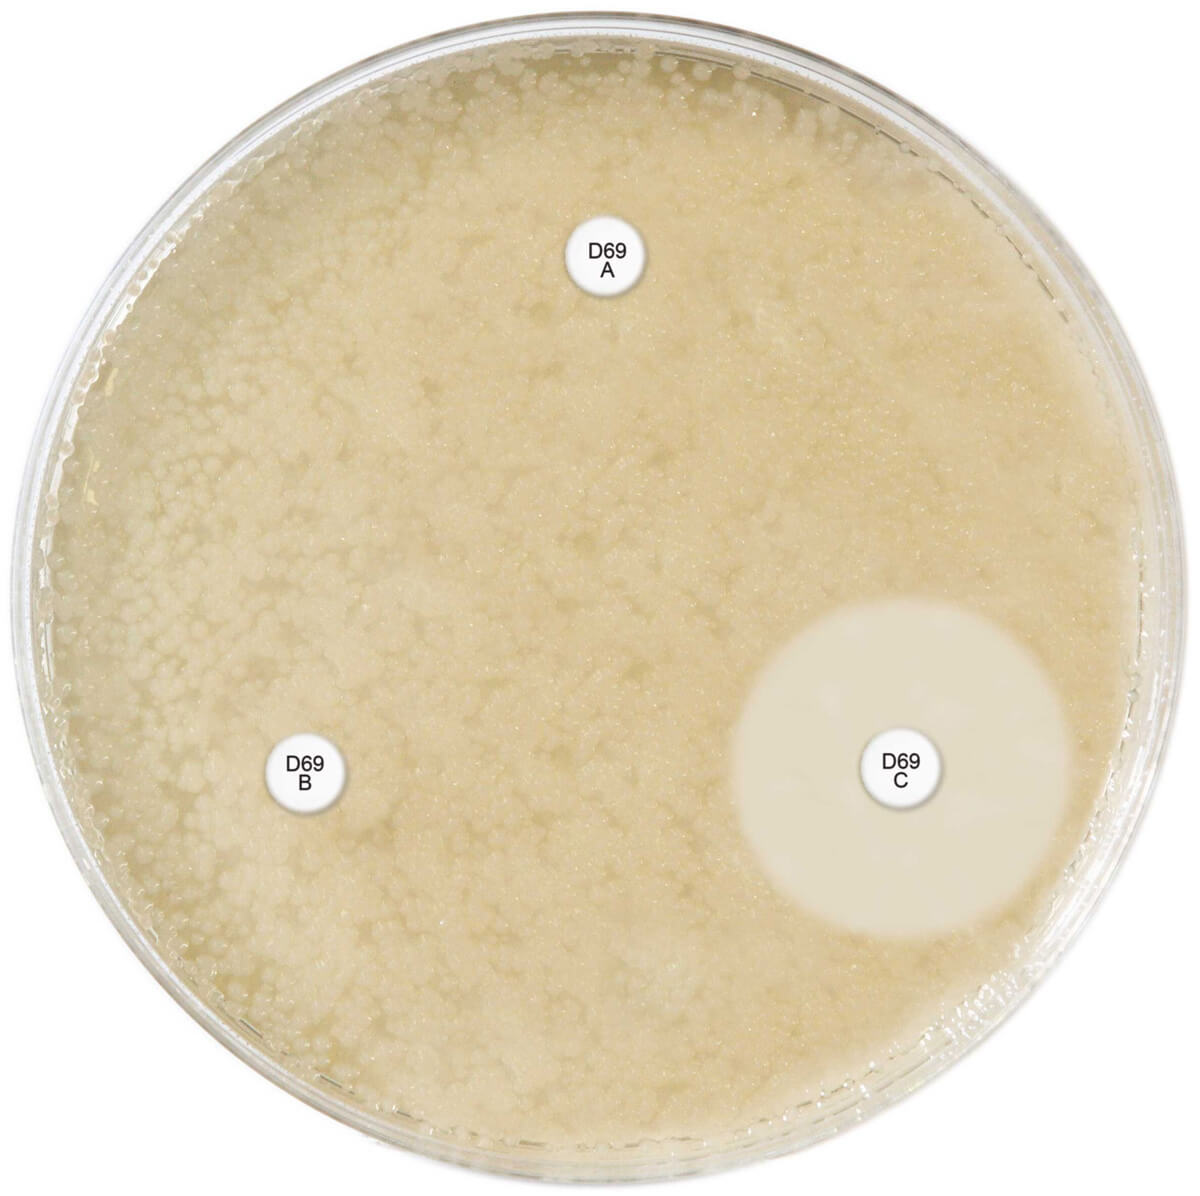
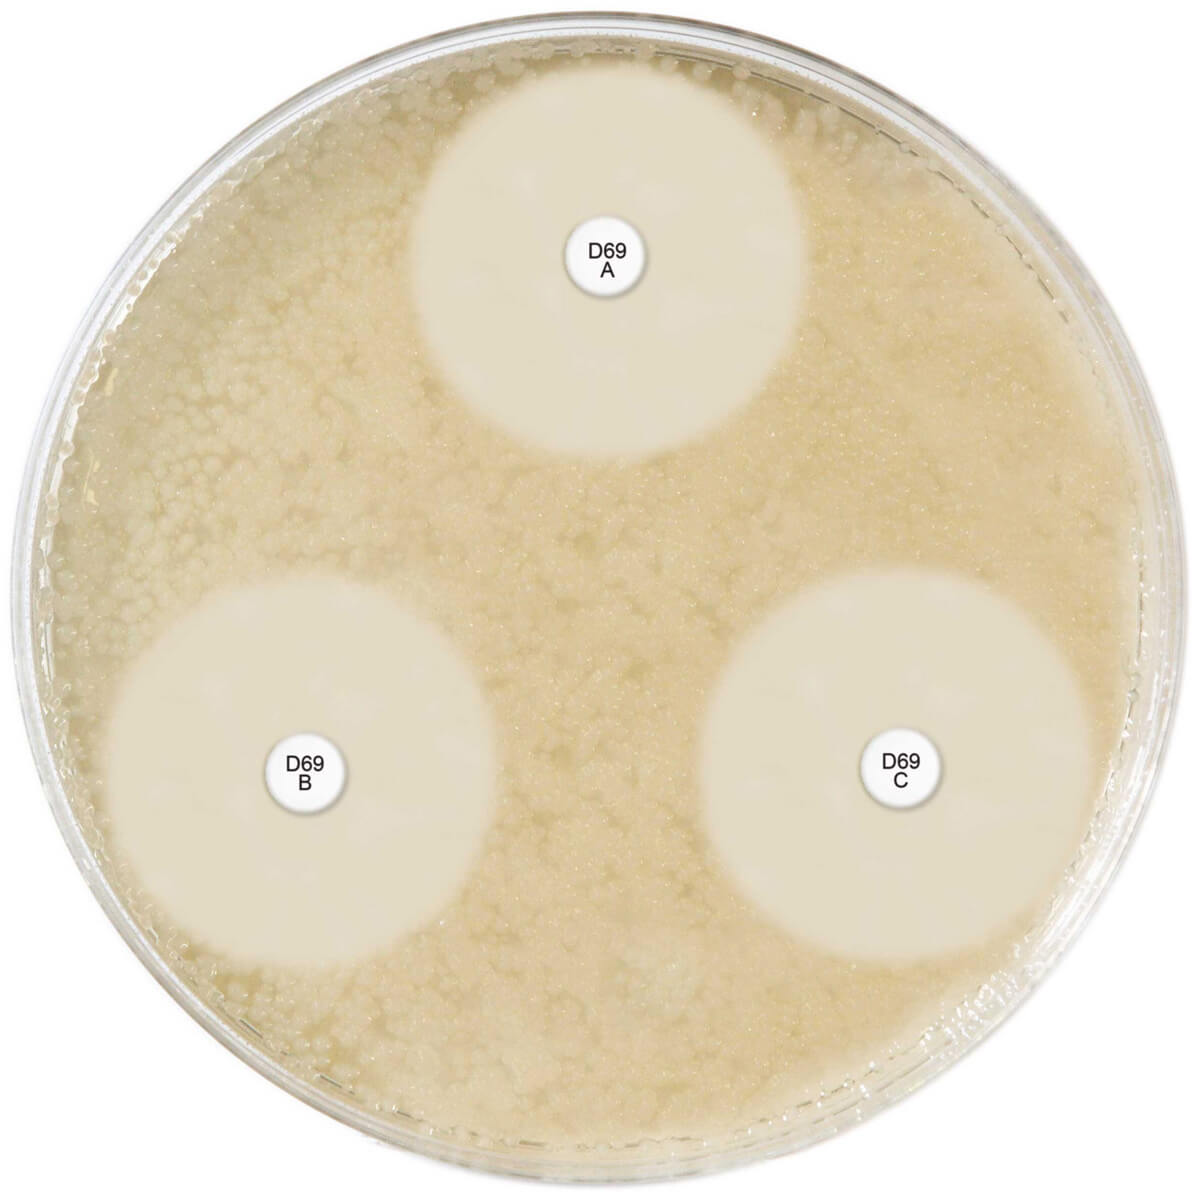

About the product
Three cartridges for the detection of AmpC β-Lactamase enzyme production
CARTRIDGE A: Cefpodoxime 10µg + AmpC inducer
CARTRIDGE B: Cefpodoxime 10µg + AmpC inducer + ESBL inhibitor
CARTRIDGE C: Cefpodoxime 10µg + AmpC inducer + ESBL inhibitor + AmpC inhibitors